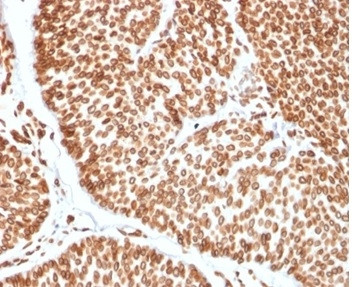
TCF4 (Transcription Factor 4) Antibody in Immunohistochemistry (Paraffin) (IHC (P))

Search
NeoBiotechnologies
TCF4 (Transcription Factor 4) Monoclonal Antibody (TCF4/2252)
{{$productOrderCtrl.translations['antibody.pdp.commerceCard.promotion.promotions']}}
{{$productOrderCtrl.translations['antibody.pdp.commerceCard.promotion.viewpromo']}}
{{$productOrderCtrl.translations['antibody.pdp.commerceCard.promotion.promocode']}}: {{promo.promoCode}} {{promo.promoTitle}} {{promo.promoDescription}}. {{$productOrderCtrl.translations['antibody.pdp.commerceCard.promotion.learnmore']}}
产品信息
6925-MSM2-P1ABX
种属反应
宿主/亚型
分类
类型
克隆号
抗原
偶联物
形式
浓度
规格
纯化类型
保存液
内含物
保存条件
运输条件
靶标信息
TCF4 is transcription factor 4, a basic helix-turn-helix transcription factor. The encoded protein recognizes an Ephrussi-box ('E-box') binding site ('CANNTG')-a motif first identified in immunoglobulin enhancers. This gene is expressed predominantly in pre-B-cells, although it is found in other tissues as well. Defects in this gene are a cause of Pitt-Hopkins syndrome.
仅用于科研。不用于诊断过程。未经明确授权不得转售。
篇参考文献 (0)
生物信息学
蛋白别名: bHLHb19; Class B basic helix-loop-helix protein 19; E2 2; Immunoglobulin transcription factor 2; ITF 2; ITF-2; MGC149723; MGC149724; SEF 2; SEF-2; SEF2 1; SEF2 1A; SEF2 1B; SL3-3 enhancer factor 2; TCF 4; TCF-4; Transcription factor 4; unnamed protein product
基因别名: BHLHB19; CDG2T; E2-2; FCD2; FECD3; ITF-2; ITF2; PTHS; SEF-2; SEF2; SEF2-1; SEF2-1A; SEF2-1B; SEF2-1D; TCF-4; TCF4
UniProt ID: (Human) P15884
Entrez Gene ID: (Human) 6925